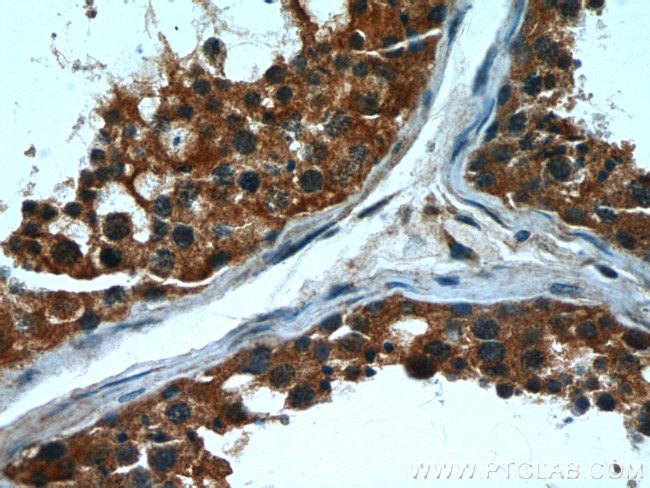
CPT1C Antibody in Immunohistochemistry (Paraffin) (IHC (P))

Search
Proteintech
CPT1C Monoclonal Antibody (5D11B5)
{{$productOrderCtrl.translations['antibody.pdp.commerceCard.promotion.promotions']}}
{{$productOrderCtrl.translations['antibody.pdp.commerceCard.promotion.viewpromo']}}
{{$productOrderCtrl.translations['antibody.pdp.commerceCard.promotion.promocode']}}: {{promo.promoCode}} {{promo.promoTitle}} {{promo.promoDescription}}. {{$productOrderCtrl.translations['antibody.pdp.commerceCard.promotion.learnmore']}}
产品信息
66072-1-IG
种属反应
已发表种属
宿主/亚型
分类
类型
克隆号
抗原
偶联物
形式
浓度
规格
纯化类型
保存液
内含物
保存条件
运输条件
产品详细信息
This antibody can bind the close sequences genes.
Immunogen sequence: SFTLIVFSN GKLGLSVEHS WADCPISGHM WEFTLATECF QLGYSTDGHC KGHPDPTLPQ PQRLQWDLPD QIHSSISLAL RGAKILSENV DCHVVPFSLF GKSFIRRCHL SSDSFIQIAL QLAHFRDRGQ FCLTYESAMT RLFLEGRTET VRSCTREACN FVRAMEDKEK TDPQCLALFR VAVDKHQALL KAAMSGQGVD RHLFALYIVS RFLHLQSPFL TQVHSEQWQL STSQIPVQQM HLFDVHNYPD YVSSGGGFGP ADDHGYGVSY IFMGDGMITF HISSKKSSTK TDSHRLGQHI EDALLDVASL FQAGQHFKRR FRGSGKENSR HRCGFLSRQT GASKASMTST DF (442-793 aa encoded by BC029104)
靶标信息
This gene encodes a member of the carnitine/choline acetyltransferase family. The encoded protein regulates the beta-oxidation and transport of long-chain fatty acids into mitochondria, and may play a role in the regulation of feeding behavior and whole-body energy homeostasis. Alternatively spliced transcript variants encoding multiple protein isoforms have been observed for this gene.
仅用于科研。不用于诊断过程。未经明确授权不得转售。
生物信息学
蛋白别名: Carnitine O-palmitoyltransferase 1, brain isoform; Carnitine palmitoyltransferase 1C; Carnitine palmitoyltransferase I; carnitine palmitoyltransferase I related C; CPT I-C; CPT IC; CPTI-B; FLJ23809; Palmitoyl thioesterase CPT1C; unnamed protein product
基因别名: CATL1; CPT I-C; CPT1-B; CPT1C; CPT1P; CPTI-B; CPTIC; SPG73
UniProt ID: (Human) Q8TCG5
Entrez Gene ID: (Pig) 100519258, (Human) 126129